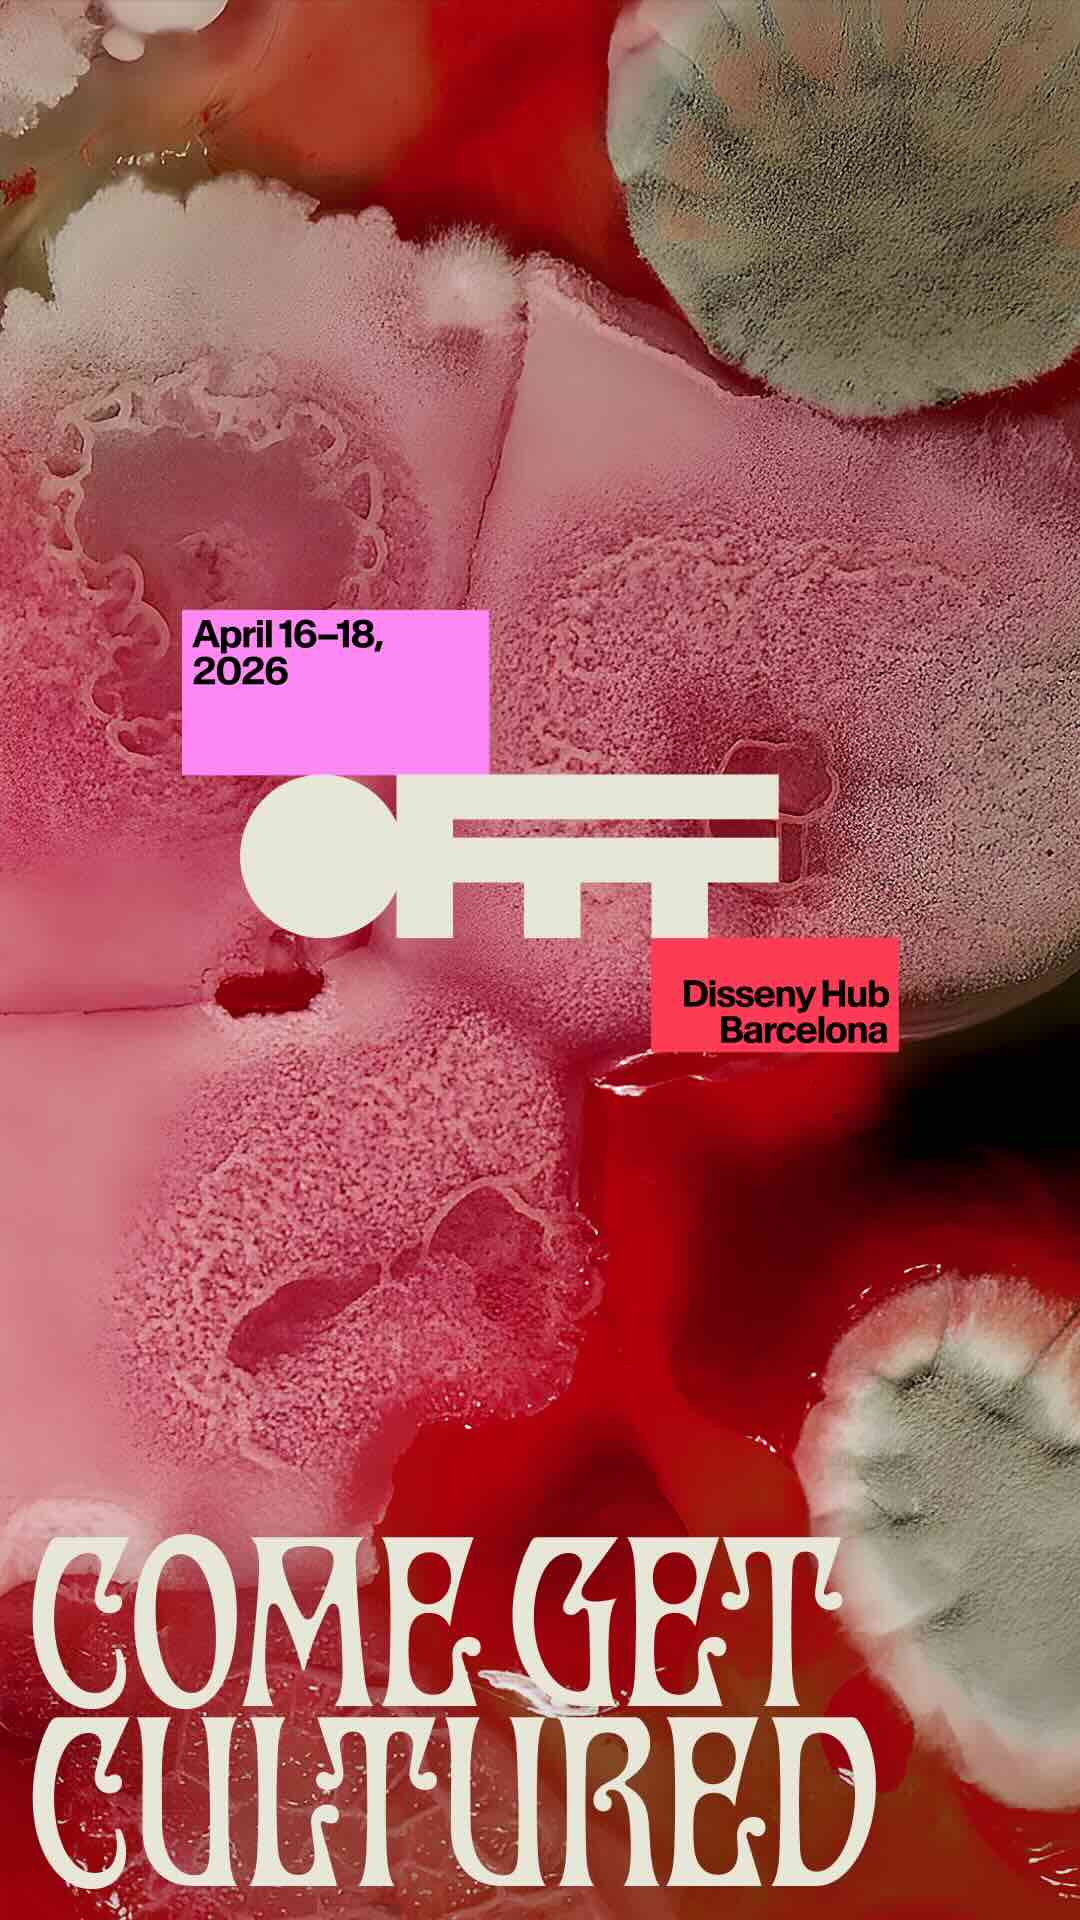

La idea de que la cultura se propaga, cambia y evoluciona como si fuera un ecosistema vivo y modelado por las personas, ha articulado la campaña publicitaria de la edición de Barcelona de OFFF, el festival internacional de creatividad, arte y diseño digital que se ha celebrado entre los días 16 y 18 de abril. Creada por Uncommon Creative Studio, lleva el concepto a su máxima expresión al recurrir al material biológico de la comunidad creativa para dar vida a todo un universo visual.
Titulada “What We Make It”, la campaña explora la cultura como fruto del intercambio de ideas, referencias y perspectivas de muchos, no solo de unos pocos; y que, como la propia vida, puede darse bajo las condiciones adecuadas de colaboración. La organización del festival ha buscado trasladar, en un paralelismo con lo que el propio evento representa, que la colaboración es el método y no el resultado; y que cuando las mentes se juntan a conversar y experimentar surgen nuevas formas de ver y entender el mundo.
El universo de la investigación química ha sido el elegido por la agencia para expresar esa visión, y dar forma la identidad gráfica del encuentro, que ha sido creada recurriendo a materiales de laboratorio y cultivos biológicos en crecimiento extraídos de la propia comunidad creativa. Según explican desde Uncommon, invitaron a profesionales del sector a sus estudios de Londres y Nueva York para una serie de sesiones en las que, además de compartir ideas, aseguran que recogieron huellas, fibras y fluidos de pomos de puertas o tazas para convertirlos en un sistema de diseño.
Las muestras recogidas se compartieron con la “bioartista” Dasha Plesen, también conocida como “Reina del Moho” por usar bacterias como material artístico. Cultivados en equipamiento de laboratorio, esos gérmenes han sido la base de una serie de formas, texturas y patrones que se han combinado con una paleta de colores inspirada en los tonos más vibrantes de la naturaleza, para crear un lenguaje visual que refleja la diversidad, la imprevisibilidad y la vitalidad de la comunidad creativa.
Ese ecosistema vivo cultivado es protagonista de las llamativas piezas gráficas que ha promocionado la cita a través de redes sociales y otros medios. Los carteles mostraban el lotogipo de OFFF, las fechas y el lugar de celebración, y el claim “Come get cultured”, en un juego de palabras entre los términos “cultivar” y “culturizar”.
Además, se ha creado una pieza en la que el logo del festival adopta la forma de una placa de Petri, reforzando la idea de que la comunidad creativa se desarrolla y crece en el marco de su propuesta.
La tipografía de la campaña, denominada Hyphae, se inspira en formas de letras experimentales y biomórficas en línea con el concepto creativo de la campaña, así como en el modernismo, un movimiento cultural que tuvo fuerte presencia en Barcelona entre finales del siglo XIX y principios del XX.
Se ha podido ver en todos los puntos de contacto del festival, desde las redes sociales, hasta la agenda de programación, pasando por la decoración de estancias.
Además, el sistema visual también se ha materializado en una colaboración con el estudio de cerámica Hal.Project, que ha creado 100 platos de cerámica Petri flos ponentes y oradores de esta edición del festival en Barcelona.
“What We Make It” pone el talento humano en el centro del mensaje y trasladando a los profesionales que la campaña, en lugar de dirigirse a ellos, nace de ellos. Desde el festival aseguran que es una celebración de la autoría y del poder del intercambio creativo y la colaboración. Y en un mercado cada vez más efímero y en el que gana presencia la inteligencia artificial, comunica que la industria la conforman las personas y su futuro puede construirse de manera conjunta.